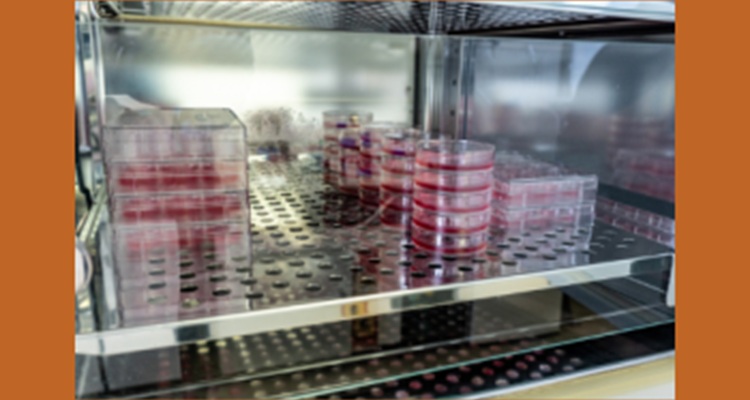

The Beginning: Fertilization Check
After retrieving the eggs from the ovaries of the female partner, the IVF procedure proceeds with insemination using sperm collected from the male partner or a donor. Subsequently, a fertilization check takes place approximately 16-20 hours after insemination. This procedure is done to assess the successful penetration of the egg by the sperm, resulting in fertilization. Skilled embryologists perform this check, identifying fertilized eggs, known as zygotes, under a microscope. Healthy fertilization constitutes a critical initial phase in embryo culture. Close monitoring of embryo quality ensures the best possible outcomes.
Embryo Quality- Grading and Selection
Following the fertilization check, embryos undergo a period of development in the IVF laboratory. Embryo grading is a meticulous process that involves evaluating the appearance and embryo quality. Embryologists use specific grading criteria to assess the number of cells, symmetry, and fragmentation levels in each embryo. This assessment helps identify the most viable embryos with the highest potential for successful implantation.
Controlled Environment: Embryo Culture
Accordingly, the IVF laboratory team places the selected embryos in a specialized culture medium within a controlled incubator for embryo culture. Additionally, this environment mimics conditions in the female reproductive tract, providing necessary nutrients and stability for embryo development. Afterwards, the team maintains optimal temperature, pH levels, and gas concentrations to create an ideal setting for embryo growth.
Embryo Quality- Day 3 vs. Day 5 Embryo Transfer
During embryo culture, a crucial decision point is whether to proceed with a Day 3 or Day 5 embryo transfer.
Day 3 transfers involve transferring the embryos into the uterus at the cleavage stage (6-8 cells). On the other hand, Day 5 transfers utilize hatching blastocysts, which are embryos on the verge of breaking out of their protective shells. The timing of the transfer is carefully chosen based on the embryo’s quality, the number of embryos available, and the patient’s medical history. Accordingly, this decision is vital for the success of the procedure.
The Marvel of Hatching Blastocysts
Hatching blastocysts are high quality embryos that are prepared to break free from their protective outer shell. This shell is called the zona pellucida. This important phase indicates that the embryo is ready for implantation in the uterine lining. Hatching blastocysts are regarded as having the highest potential for successful implantation. This makes them a preferred option for transfer in IVF procedures.
Enhanced Success Rates and Pregnancy Outcomes
The embryo culture process in IVF laboratories has evolved significantly over the years, resulting in improved success rates and pregnancy outcomes. By closely monitoring and optimizing the embryo’s growth conditions, embryologists can better select the most viable embryos for fresh or frozen transfer. This targeted approach significantly increases the chances of a successful pregnancy for hopeful parents undergoing IVF treatments. In essence, advancements in embryo culture have brought about positive changes in IVF success rates and enhanced the prospects of parenthood for many couples.
The embryo culture process in IVF laboratories has evolved significantly over the years, leading to improved success rates and pregnancy outcomes. By closely monitoring and optimizing the embryo’s growth conditions, embryologists can better select the most viable embryos for transfer. This targeted approach significantly increases the chances of a successful pregnancy for hopeful parents undergoing IVF treatments.